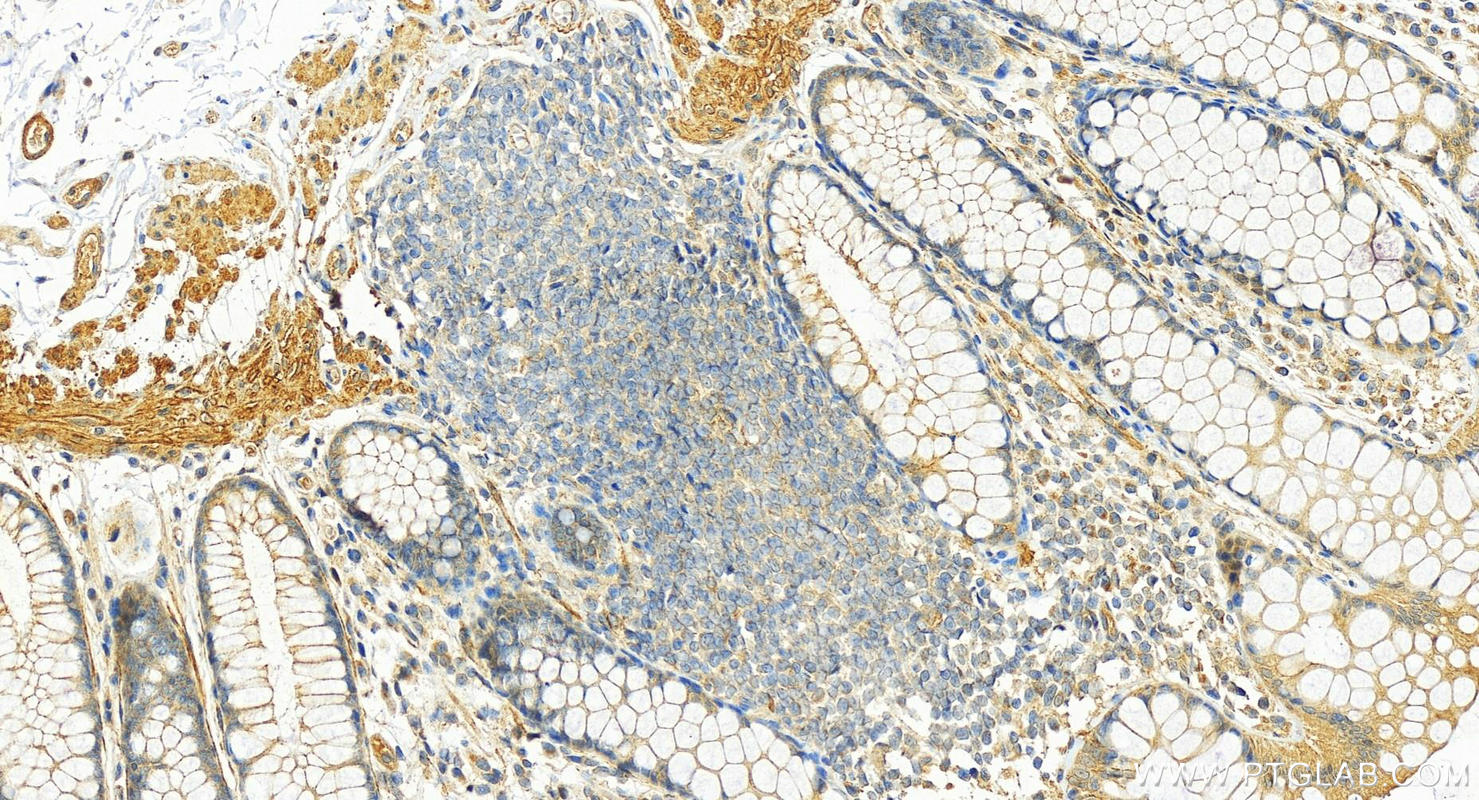

验证数据展示
经过测试的应用
| Positive WB detected in | 3T3-L1 cells, HEK-293 cells, mouse kidney tissue, mouse liver tissue |
| Positive IP detected in | mouse liver tissue |
| Positive IHC detected in | human stomach tissue, human colon tissue Note: suggested antigen retrieval with TE buffer pH 9.0; (*) Alternatively, antigen retrieval may be performed with citrate buffer pH 6.0 |
推荐稀释比
| 应用 | 推荐稀释比 |
|---|---|
| Western Blot (WB) | WB : 1:500-1:1000 |
| Immunoprecipitation (IP) | IP : 0.5-4.0 ug for 1.0-3.0 mg of total protein lysate |
| Immunohistochemistry (IHC) | IHC : 1:50-1:500 |
| It is recommended that this reagent should be titrated in each testing system to obtain optimal results. | |
| Sample-dependent, Check data in validation data gallery. | |
产品信息
13854-1-AP targets SORBS1 in WB, IHC, IF, IP, ELISA applications and shows reactivity with human, mouse samples.
| 经测试应用 | WB, IHC, IP, ELISA Application Description |
| 文献引用应用 | WB, IHC, IF |
| 经测试反应性 | human, mouse |
| 文献引用反应性 | human, mouse, canine |
| 免疫原 |
CatNo: Ag4828 Product name: Recombinant human SORBS1 protein Source: e coli.-derived, PGEX-4T Tag: GST Domain: 1-300 aa of BC042612 Sequence: MSSECDGGSKAVMNGLAPGSNGQDKDMDPTKICTGKGAVTLRASSSYRETPSSSPASPQETRQHESKPDEWRLSSSADANGNAQPSSLAAKGYRSVHPNLPSDKSQDATSSSAAQPEVIVVPLYLVNTDRGQEGTARPPTPLGPLGCVPTIPATASAASPLTFPTLDDFIPPHLQRWPHHSQPARASGSFAPISQTPPSFSPPPPLVPPAPEDLRRVSEPDLTGAVSSTDSSPLLNEVSSSLIGTDSQAFPSVSKPSSAYPSTTIVNPTIVLLQHNREQQKRLSSLSDPVSERRVGEQDS 种属同源性预测 |
| 宿主/亚型 | Rabbit / IgG |
| 抗体类别 | Polyclonal |
| 产品类型 | Antibody |
| 全称 | sorbin and SH3 domain containing 1 |
| 别名 | CAP, c-Cbl-associated protein, SH3D5, SORB1, Sorbin and SH3 domain-containing protein 1 |
| 计算分子量 | 1292 aa, 142 kDa |
| 观测分子量 | 70-75 kDa |
| GenBank蛋白编号 | BC042612 |
| 基因名称 | SORBS1 |
| Gene ID (NCBI) | 10580 |
| RRID | AB_11232224 |
| 偶联类型 | Unconjugated |
| 形式 | Liquid |
| 纯化方式 | Antigen affinity purification |
| UNIPROT ID | Q9BX66 |
| 储存缓冲液 | PBS with 0.02% sodium azide and 50% glycerol, pH 7.3. |
| 储存条件 | Store at -20°C. Stable for one year after shipment. Aliquoting is unnecessary for -20oC storage. |
背景介绍
The sorbin homology (SoHo) family of adapter and scaffold proteins consists of three proteins: CAP, also known as Sorbin and SH3 domain containing 1 (Sorbs1), ArgBP2, also known as Sorbs2, and Vinexin, also known as Sorbs3. All Sorbs proteins are highly expressed in heart tissue, skeletal muscle, adipose tissue, and cells of the immune system, functioning as SH3-domain-mediated adaptors of scaffolding molecules(PMID: 32738595). SORBS1 can bind to signaling molecules (e.g., c-Cbl, c-Abl, and insulin reporter) to regulate glucose transport, transcription activity, and insulin signaling(PMID: 27791200).
实验方案
| Product Specific Protocols | |
|---|---|
| IHC protocol for SORBS1 antibody 13854-1-AP | Download protocol |
| IP protocol for SORBS1 antibody 13854-1-AP | Download protocol |
| WB protocol for SORBS1 antibody 13854-1-AP | Download protocol |
| Standard Protocols | |
|---|---|
| Click here to view our Standard Protocols |
发表文章
| Species | Application | Title |
|---|---|---|
Front Cell Dev Biol Long Non-coding RNAs LOC100126784 and POM121L9P Derived From Bone Marrow Mesenchymal Stem Cells Enhance Osteogenic Differentiation via the miR-503-5p/SORBS1 Axis.
| ||
Oncol Res SORBS1 Knockdown Resists S/G2 Arrest and Apoptosis Caused by Polyphyllin H-Induced DNA Damage in Pancreatic Cancer
| ||
Front Cell Neurosci Integrative Cell Type-Specific Multi-Omics Approaches Reveal Impaired Programs of Glial Cell Differentiation in Mouse Culture Models of DM1. | ||
PLoS One Sorbin and SH3 domain-containing protein 2 (SORBS2) is a component of the acto-myosin ring at the apical junctional complex in epithelial cells. | ||
Sci Rep STAP-2 facilitates insulin signaling through binding to CAP/c-Cbl and regulates adipocyte differentiation | ||
PLoS One Proteomic changes in the hippocampus of large mammals after total-body low dose radiation |